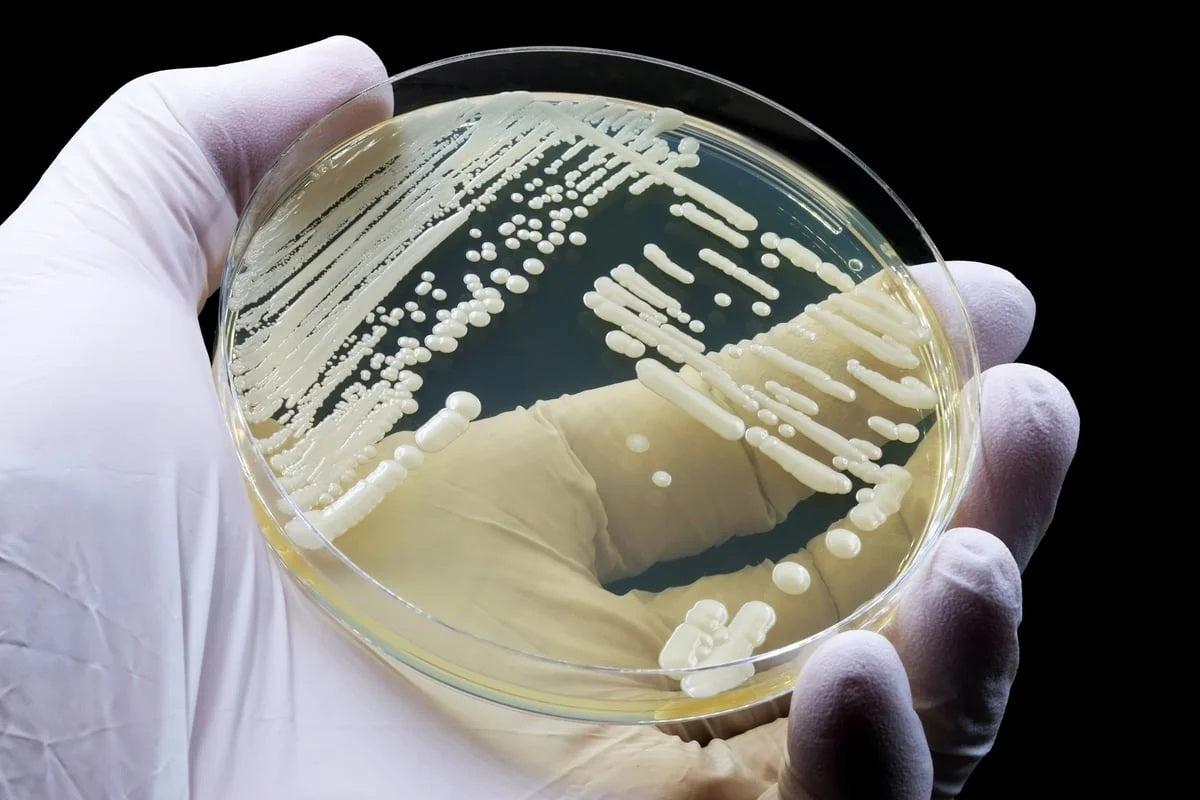

BY ECRI PRESIDENT AND CEO, DR. MARCUS SCHABACKER, MD, PHD
Healthcare-associated infections (HAI’s) wreak havoc on healthcare institutions and patients across the U.S. The human toll is devastating and so is the economic cost.
HAI’s cause more than 72,000 deaths of hospitalized patients annually. Up to 70% of HAI’s are considered preventable when using evidence-based practices in hand hygiene, sterilization, and antimicrobial stewardship. Each year, hospitals incur $28.4 billion to $45 billion in direct medical costs due to HAIs. ECRI has sounded the alarm on this issue for many years. The persistence of hospital-acquired infections in long-term care settings was one of our Top Ten Patient Safety Concerns for 2025.
Considering the toll this takes on health systems and patients, it is essential that healthcare providers nationwide receive consistent, science-backed guidance to prevent the spread of infections.
For over 30 years, the CDC’s Healthcare Infection Control Practices Advisory Committee (HICPAC) played a vital role in shaping national standards for infection prevention in healthcare settings. The recent move by HHS to dissolve the CDC’s HICPAC is deeply concerning. Dissolving the committee so soon after a global pandemic that claimed millions of lives raises concerns that critical lessons from COVID-19 may be fading from focus.
I urge HHS to consider: what will replace the advisory committee to ensure healthcare providers access and implement up-to-date, evidence-based practices to stop the spread of HAI’s?
When it comes to chronic challenges in healthcare like infection prevention, abolishing national resources seems to send a troubling message to healthcare leaders when lives are on the line: do more with less.
ECRI is a trusted, independent partner to health systems, government agencies, manufacturers, payors and many others around the world, providing expertise to meet the demands of the moment. With six decades of experience, we continue to offer transformative insights into patient safety that enable better care.

ECRI was accepted as a liaison representative for HICPAC in 2024 and was slated to begin filling this role in 2025 before the committee was dissolved. HICPAC liaisons represent health-related associations, consumer groups, public organizations, and government partners.
Infection Prevention Resources from ECRI

How to Prevent the Spread of Infection in Healthcare Settings

Environmental Cleaning and Disinfection: Break the Chain of Infection

Four Ways to Prevent and Control Hospital-Acquired Infections

New Water Quality Standards for Medical Device Processing

What Hospitals Need to Know: Using Water During Processing of Medical Devices
How to Respond to Outbreaks of Candida Auris Cases

Hand Hygiene: Fundamentals to Prevent HAIs

Drug Diversion and Infection Prevention: When the Needle Hits the Vein
